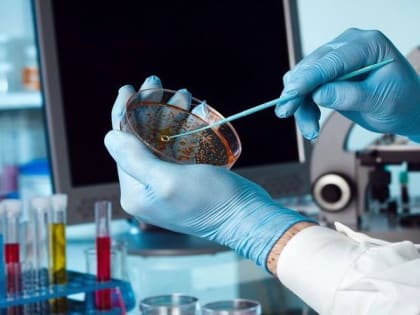
Аскаридоз – один из самых распространенных гельминтозов человека!

Здоровье

Свердловские власти готовы вернуть возможность дистанционного социального обслуживания детей с ОВЗ
ЕКАТЕРИНБУРГ. Министерство социальной политики рассмотрит возможность возвращения дистанционного формата оказания психологических и социально-педагогических услуг детям с ограниченными возможностями здоровья.

Заболевания печени!
Будьте внимательны: симптомы заболеваний печени не специфичны, пациента может ничего не беспокоить.
Аскаридоз – один из самых распространенных гельминтозов человека!
Заражение происходит при употреблении в пищу плохо промытых овощей, фруктов, ягод, зелени.

Каждый четвертый житель Екатеринбурга боится путешествовать из-за новых вирусов и агрессии иностранцев
Жители Екатеринбурга боятся путешествовать из-за риска появления нового вируса, негативного отношения местных жителей и сложностей с возвращением на родину.

Температура воздуха прогреется до +28 к началу августа.
В Первоуральск придет долгожданная жара.

В Каменске-Уральском будут бесплатно лечить пациентов с гепатитом в дневных стационарах
В 2023 году пациенты из Каменска-Уральского с хроническими вирусными гепатитами смогут пройти лечение в дневном стационаре за счет средств ОМС.

С 24 по 30 июля — неделя профилактики заболеваний печени (в честь Международного дня гепатита 28 июля)
Проблема вирусных гепатитов продолжает оставаться крайне актуальной.

На Урале главный нарколог создал уникальную «схему обогащения» на наркозависимых пациентах
В Свердловской области создана уникальная «схема обогащения» небольшой группы наркологов на пациентах, которым требуется клиническое лечение от наркотической зависимости.

Еще четыре свердловские больницы начнут лечить пациентов с хроническими вирусными гепатитами в дневных стационарах
ЕКАТЕРИНБУРГ. Еще четыре больницы региона начнут лечить пациентов с хроническими вирусными гепатитами в условиях дневного стационара за счет средств ОМС в 2023 году.

Медики в Екатеринбурге спасли жителя Нижнего Тагила с перитонитом и сепсисом
Свердловские медики спасли тагильчанина с гнойным перитонитом, осложнённым сепсисом.